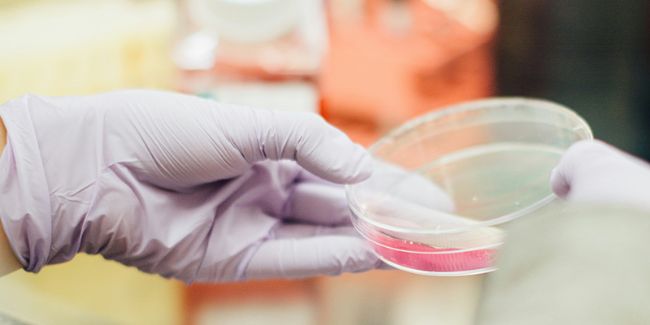

在微生物研究、生物醫(yī)藥研發(fā)、食品衛(wèi)生檢測等領(lǐng)域,活菌計數(shù)是銜接 “實驗設(shè)計 - 結(jié)果驗證” 的關(guān)鍵環(huán)節(jié)——監(jiān)測菌株傳代中的活性穩(wěn)定性、評估抑菌藥物的半數(shù)抑制濃度(IC50)、驗證食品加工后微生物殘留量,都需要以精準的活菌濃度、活率數(shù)據(jù)為依據(jù)。但長期以來,傳統(tǒng)活菌計數(shù)方法的固有局限,不僅制約了工作效率,還無法解決數(shù)據(jù)可靠性這一痛點。
傳統(tǒng)手動菌落計數(shù)法的流程鏈條長:需先對細菌懸液進行梯度稀釋,再均勻鋪于固體培養(yǎng)基,之后還要經(jīng)歷過夜甚至數(shù)天的恒溫培養(yǎng)。不僅占用大量時間,后續(xù)計數(shù)時還可能因菌落重疊、邊緣模糊,或培養(yǎng)箱內(nèi)溫度 / 濕度不均導致菌落生長差異,最終引入 ±10%-15% 的計數(shù)誤差;而常用的OD值檢測法,本質(zhì)是通過 “吸光度-濃度” 標準曲線間接估算,既無法區(qū)分活菌與死菌(死菌細胞壁碎片同樣會產(chǎn)生吸光度),還會因菌株形態(tài)差異、懸液均一性不足導致數(shù)據(jù)波動,難以滿足高精度實驗或檢測需求。

針對這些實際需求,博大博聚微生物細胞計數(shù)儀通過顯微成像技術(shù),提供了一套更適配、更高效的實驗場景的解決方案。該儀器搭載20X光學成像系統(tǒng)、1000 萬高分辨率 CMOS 與雙色熒光通道,配合微生物特異性熒光染料(活菌被染為綠色,死菌被染為紅色),可清晰捕獲單個細菌的熒光信號,避免傳統(tǒng)方法中 “群體估算” 的局限性。

從操作流程來看,該儀器的核心優(yōu)勢在于 “簡化預處理與標準化操作”:無需對細菌懸液進行離心富集或沉降處理,僅需兩步即可完成樣品準備——先取 5μL 細菌懸液與 5μL 微生物雙色熒光染液 1:1 混勻;再吸取 5μL 染色后的混合液,滴加至配套的細菌計數(shù)板(計數(shù)室高度為 5μm),再將細菌計數(shù)板置于儀器載物臺。后續(xù)僅需在軟件中錄入樣品編號等基礎(chǔ)信息,點擊 “開始分析”,儀器便會自動完成圖像采集、細菌識別與數(shù)據(jù)計算,整個過程無需鋪板、無需等待培養(yǎng),幾分鐘內(nèi)即可輸出高清熒光圖像及活菌濃度、活率、細菌直徑分布等參數(shù),大幅縮短了從 “樣品處理” 到 “數(shù)據(jù)輸出” 的周期。
在數(shù)據(jù)可靠性方面,該儀器的設(shè)計邏輯圍繞 “直接計數(shù)-精準識別” 展開:不同于傳統(tǒng)方法的 “間接推導”,其通過雙色熒光通道區(qū)分活菌與死菌信號,再利用智能算法對每個熒光標記的活菌進行逐一識別(可自動排除雜質(zhì)顆粒干擾),最終可自動補償 1:1 染色的稀釋倍數(shù),直接輸出原始細菌懸液的活菌濃度(單位:viable cells/mL),無需人工換算。其計數(shù)結(jié)果的重復性與穩(wěn)定性均優(yōu)于傳統(tǒng)方法,能滿足科研論文數(shù)據(jù)溯源、藥品研發(fā)中 GMP 合規(guī)檢測等對數(shù)據(jù)精度的嚴格要求。
儀器實拍案例圖






面對活菌計數(shù)的效率與精度難題,博大博聚微生物細胞計數(shù)儀可切實化解痛點。其簡化流程、精準計數(shù)的特性,適配科研、藥企、檢測等多場景需求。若想了解菌株適配方案或流程銜接細節(jié),可進一步咨詢,為實驗與檢測提效賦能。